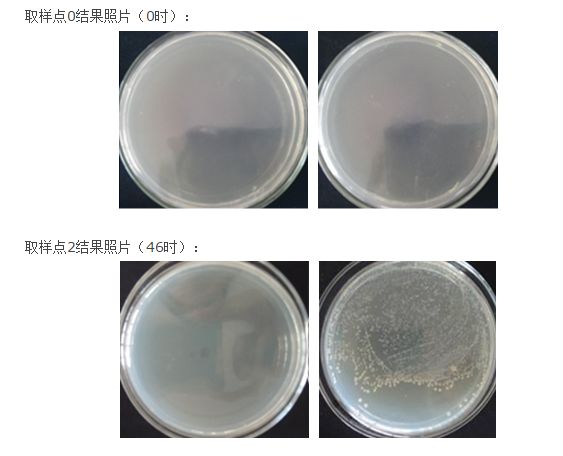
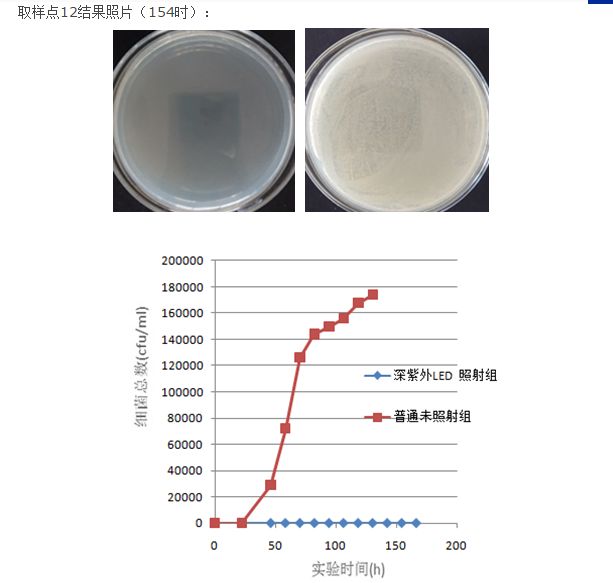

Hotlines:400-998-2069
LED固化设备:18025158959

| UVC LED抑菌灭菌领域市场前景光明 |
| 发布时间:2015-05-26 信息来源:www.lantuo.org 发布人:UVLED 点击次数:5596 |
无论净水器还是饮水机,在初始状态,水质中的微生物指标都是合格的,但是伴随着使用过程,时间一久都会不同程度地滋生细菌,严重地情况下会造成所谓的二次污染,危及到净水器和饮水机的正常使用。 UVB波段,波长280~315nm,又称为中波红斑效应紫外线 。UVB紫外线对人体具有红斑作用,少剂量短时间的照射能促进体内矿物质代谢和维生素D的形成,UVB具有一定的杀菌能力。 UVC波段,波长100~280nm,又称为短波灭菌紫外线,可高效杀灭各种微生物,包括细菌繁殖体、芽胞、分支杆菌、病毒、真菌、立克次氏和支原体等,凡被上述微生物污染的表面、水和空气均可采用UVC波段紫外线杀菌,其杀菌效率可高达99%以上,也因为其高效杀菌的特性,UVC被广泛应用于医疗、卫生、民用等领域。 深紫外(UVC) LED杀菌 紫外线杀菌是通过紫外线的照射,破坏微生物的DNA(脱氧核糖核酸)或RNA(核糖核酸)分子结构,使细菌死亡或不能繁殖,达到杀菌的目的。真正具有杀菌作用的是UVC紫外线,因为C波段紫外线很易被生物体的DNA吸收,尤以265 ~ 280nm左右的紫外线最佳。
深紫外LED抑菌杀菌模块较传统抑菌杀菌方法具有:
通过以上照射(抑菌)组和对照组对比实验的数据可以明确看出,未加抑菌模块的对照组细菌总数在第3天已达到28800cfu/ml,远超过国家生活饮用水卫生标准中的细菌限值,而增加抑菌模块的照射(抑菌)组在实验时间内细菌总数一直保持为0cfu/ml,完全符合国家生活饮用水卫生标准中的细菌限值。该实验充分说明“280nm深紫外LED”抑菌模块可使用较小剂量的紫外线达到高效的抑菌效果。 光华士公司将陆续推UVC LED深紫外系列产品,敬请关注!我司主营为UVLED、大功率紫光led模组、3535紫光led、940nm红外线led、850nm红外LED、730nm红外led、660nm植物灯等,接受非标光源、特殊波长、任一功率产品的订制生产。全球服务热线:400-998-2069 |